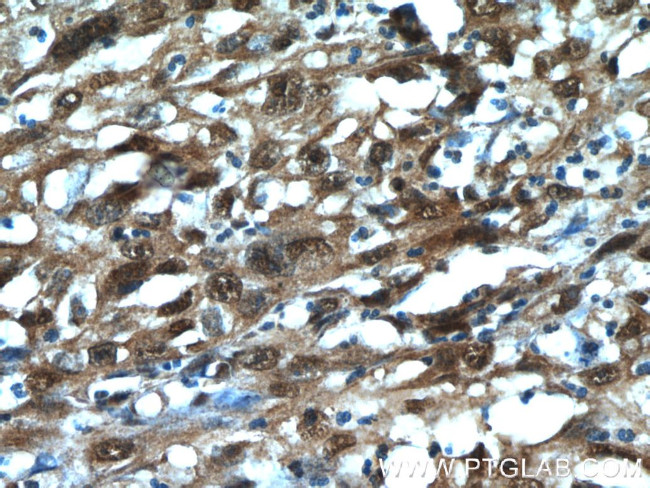
MCL1L Antibody in Immunohistochemistry (Paraffin) (IHC (P))

Search
Proteintech
MCL1L Polyclonal Antibody
{{$productOrderCtrl.translations['antibody.pdp.commerceCard.promotion.promotions']}}
{{$productOrderCtrl.translations['antibody.pdp.commerceCard.promotion.viewpromo']}}
{{$productOrderCtrl.translations['antibody.pdp.commerceCard.promotion.promocode']}}: {{promo.promoCode}} {{promo.promoTitle}} {{promo.promoDescription}}. {{$productOrderCtrl.translations['antibody.pdp.commerceCard.promotion.learnmore']}}
产品信息
15825-1-AP
种属反应
宿主/亚型
分类
类型
抗原
偶联物
形式
浓度
规格
纯化类型
保存液
内含物
保存条件
运输条件
产品详细信息
This antibody is specific to MCL1L isoform.
靶标信息
MCL1 (Myeloid cell leukemia-1) belongs to the Bcl-2 family and is involved in programing, differentiation and concomitant maintenance of cell viability, but not of proliferation. Isoform 1 of MCL1 inhibits apoptosis while isoform 2 promotes it. The carboxy terminal of MCL1 and bcl-2 share significant sequence homology. Expression of MCL1 is increased upon exposure of ML-1 cells to various types of DNA damaging agents (e.g. ionizing radiation, ultraviolet radiation, and alkylating drugs) along with increases in GADD45 and Bax and a decrease in bcl-2. Enhanced expression of MCL1, prominently associated with mitochondria, complements the continued expression of bcl-2 in ML-1 cells undergoing differentiation. Like bcl-2, MCL1 has the capacity to promote cell viability under conditions that otherwise cause apoptosis. While the mechanism by which MCL1 inhibits apoptosis is not known, it is thought that it may heterodimerize and neutralize pro-apoptotic members of the Bcl-2 family such as Bim or Bak. MCL1 was originally identified in differentiating myeloid cells, but has since been shown to be expressed in multiple cell types. MCL1 is essential for embryogenesis and for the development and maintenance of B and T lymphocytes in animals. MCL1 exists as at least two distinct isoforms designated MCL1L and MCL1S. In marked contrast to the larger isoform of MCL1, overexpression of MCL1S promotes cell death.
仅用于科研。不用于诊断过程。未经明确授权不得转售。
篇参考文献 (0)
生物信息学
蛋白别名: anti-apoptotic; Bcl-2-like protein 3; Bcl-2-related protein EAT/mcl1; BCL2 family apoptosis regulator; Bcl2-L-3; Induced myeloid leukemia cell differentiation protein Mcl-1; Induced myeloid leukemia cell differentiation protein Mcl-1 homolog; MCL-1ES; MCL-1S; Mcl-1S; Bcl-2 family protein; proapoptotic protein; MCL1, BCL2 family apoptosis regulator; mcl1/EAT; MGC104264; MGC1839; myeloid cell leukemia 1; myeloid cell leukemia ES; myeloid cell leukemia sequence 1 (BCL2-related); unnamed protein product
基因别名: AW556805; bcl2-L-3; BCL2L3; EAT; Mcl-1; MCL1; MCL1-ES; mcl1/EAT; MCL1L; MCL1S; TM
UniProt ID: (Human) Q07820, (Mouse) P97287, (Rat) Q9Z1P3
Entrez Gene ID: (Human) 4170, (Mouse) 17210, (Rat) 60430